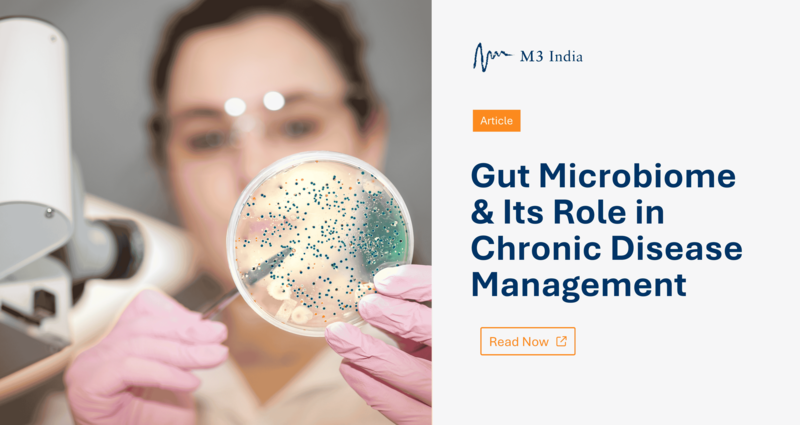

Article: Gut Microbiome & Its Role in Chronic Disease Management
M3 India Newsdesk Apr 09, 2025
The human body hosts trillions of microorganisms, especially in the gut. These gut microbiomes play many important roles in keeping us healthy. The function of gut microbiota in chronic illnesses is described in this article.
The Gut Microbiome
The gut microorganisms, collectively known as the microbiome, have more than 3 million genes and play many important roles in keeping us healthy. The gut microbiota comprises five major types of bacteria: Firmicutes, Bacteroidetes, Actinobacteria, Proteobacteria, and Verrucomicrobia. Among them, Firmicutes (including Ruminococcus, Clostridium, Lactobacillus, Eubacterium, Faecalibacterium, and Roseburia) and Bacteroidetes (including Bacteroides, Prevotella, and Xylanibacter) are the most common, making up about 90% of all gut bacteria.
Most of these bacteria live without oxygen (anaerobic) and thrive in different parts of the gut, especially the colon, where they form complex interactions with the host. These microorganisms support many functions, such as strengthening the gut barrier, supporting the immune system, helping digestion, producing vitamins, and sending signals to other parts of the body. Some of the substances they make, like lipopolysaccharides (LPS) and peptidoglycan, can trigger responses in the body by interacting with immune receptors called toll-like receptors (TLRs).
Gut Microbiome & Chronic Diseases
1. Atopic Asthma
Gut microbiota can play a role in the development of allergic diseases like atopic asthma. Asthma is a long-term lung condition where the airways become inflamed and react strongly to allergens, often due to an overactive immune response (Th2 type). This causes symptoms like wheezing, breathlessness, and coughing.
Gut bacteria affect this process by making short-chain fatty acids (SCFAs) such as butyrate, acetate, and propionate. These SCFAs help immune cells called regulatory T cells (Tregs) that calm down overactive immune reactions, including the ones seen in asthma.
The gut microbiota formed early in life—during birth, breastfeeding, exposure to antibiotics, and diet—has a big impact. Babies who lack good bacteria like Bifidobacterium and Faecalibacterium may have a higher risk of developing asthma as they grow older.
2. Behavioral and Mental Disorders
The gut-brain axis refers to the tight relationship between the gut and the brain. Imbalances in gut bacteria (a condition called dysbiosis) have been linked to mental and behavioral disorders like anxiety, depression, autism spectrum disorder (ASD), and schizophrenia.
Gut bacteria produce chemicals like serotonin, dopamine, and gamma-aminobutyric acid (GABA), which affect how the brain works. Interestingly, about 90% of the body’s serotonin is produced in the gut, showing how important gut microbes are for mental health.
The gut also connects to the brain through the vagus nerve, a direct nerve link that allows fast communication. If the gut becomes “leaky” due to dysbiosis, harmful substances and inflammatory molecules can get into the bloodstream and cause inflammation in the brain, which is thought to play a role in many brain-related disorders.
3. Irritable Bowel Syndrome (IBS)
IBS is a common gut disorder that causes pain, bloating, and irregular bowel movements. It has been linked to changes in the gut microbiome.
People with IBS often have more Firmicutes, Ruminococcus, Clostridium, and Dorea, and fewer helpful bacteria like Bifidobacterium and Faecalibacterium. Some harmful groups, like Proteobacteria, Enterobacteriaceae, and Bacteroides, are increased, which may be related to past infections or gut imbalances.
These bacteria can produce substances that cause classic IBS symptoms like gas, pain, and diarrhoea. On the other hand, certain bacteria like Faecalibacterium prausnitzii make butyrate, a helpful compound that protects the gut lining and reduces inflammation. Their presence is linked to milder IBS symptoms.
4. Non-alcoholic fatty Liver Disease (NAFLD)
NAFLD is a liver condition where fat builds up in the liver of people who don’t drink much alcohol. The gut microbiome plays a big role in this condition.
When the gut bacteria are unbalanced, the intestinal barrier can become weak, allowing harmful substances like LPS (a bacterial toxin) to enter the blood and travel to the liver. These substances activate the liver's immune cells (Kupffer cells), leading to inflammation and liver cell damage. This can cause the disease to worsen from simple fat buildup (steatosis) to a more serious stage called non-alcoholic steatohepatitis (NASH).
Gut bacteria also affect how food and bile acids are broken down, which can lead to more fat in the liver and affect how the body handles insulin. Helpful bacteria that produce SCFAs can protect the liver by reducing inflammation and strengthening the gut barrier. A drop in these good bacteria can make liver problems worse.
In NAFLD, there is an increase in harmful bacteria like Proteobacteria, Enterobacteriaceae, Collinsella, Escherichia, and Dorea, while there is a decrease in beneficial types like Coprococcus, Eubacterium, Faecalibacterium, and Prevotella.
Gut Microbiota & COVID-19
- The gut microbiome may even influence how sick someone becomes with COVID-19.
- Research has found that people with more severe COVID-19 symptoms have lower levels of helpful bacteria, such as Faecalibacterium prausnitzii, Eubacterium rectale, and Bifidobacterium adolescentis.
- These bacteria have anti-inflammatory effects and support the immune system.
- The imbalance of bacteria in COVID-19 patients was linked to higher levels of inflammatory substances and markers of tissue damage, such as C-reactive protein.
- These findings suggest that boosting levels of good gut bacteria could help lower the risk of severe illness in infections like COVID-19.
Faecal Microbiota Transplantation (FMT)
- FMT is a treatment where stool from a healthy person is transferred into the gut of someone with an illness.
- It has been used for various conditions, including infections, digestive diseases, and even mental health issues.
- In people with obesity and metabolic syndrome, receiving FMT from a healthy, lean donor improved how their body handled insulin.
- This improvement was related to changes in blood chemicals, such as higher levels of GABA, tryptophan, and phenylalanine—all of which play roles in brain and metabolic health.
Take-home Message
The gut microbiome is a complex and essential part of human health. Its influence goes far beyond digestion—it affects the immune system, mental health, metabolism, and the risk of developing many chronic diseases. From asthma and IBS to liver disease and even viral infections like COVID-19, the balance of gut bacteria plays a central role in how our body responds to disease.
Treatments like probiotics, dietary changes, and FMT offer promising ways to restore a healthy microbiome and improve outcomes in these conditions. Keeping gut microbes balanced could be one of the most important steps toward better overall health.
Disclaimer: The views and opinions expressed in this article are those of the author and do not necessarily reflect the official policy or position of M3 India.
About the author of this article: Dr Suresh Kanna, MD (General Medicine), is a consultant physician from Chennai.
-
Exclusive Write-ups & Webinars by KOLs
-
Daily Quiz by specialty
-
Paid Market Research Surveys
-
Case discussions, News & Journals' summaries